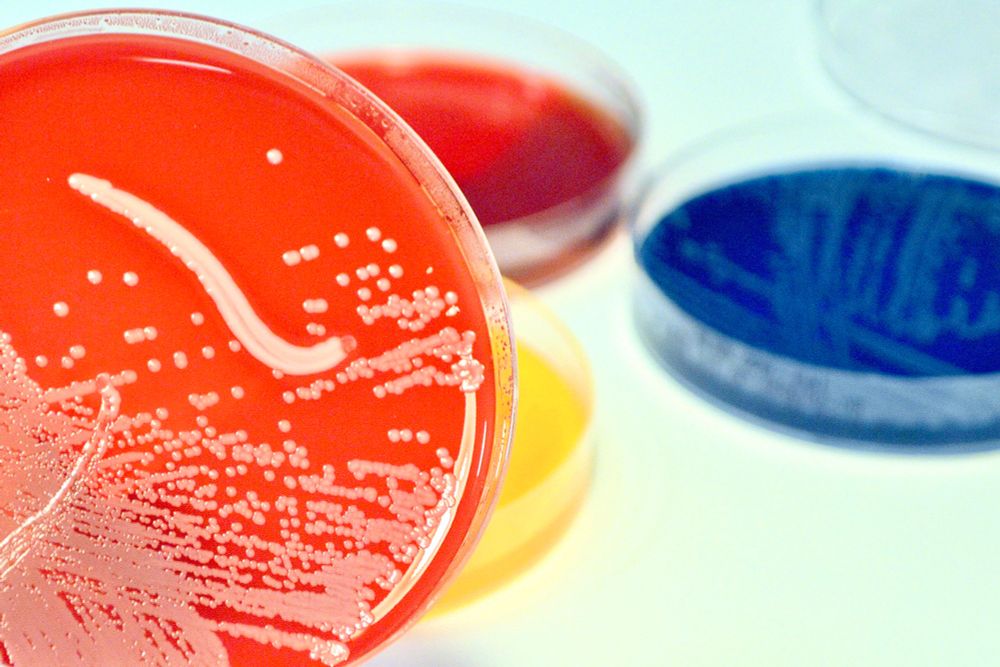

www.prnewswire.com/news-release...

www.prnewswire.com/news-release...
Catch the livestream recording here: iti.stanford.edu/iti-events/2...

Catch the livestream recording here: iti.stanford.edu/iti-events/2...
"Afucosylation of anti-dengue IgG is associated with enhanced susceptibility to dengue virus infection postvaccination"
www.science.org/doi/10.1126/...
@wanglaboratory.bsky.social

"Afucosylation of anti-dengue IgG is associated with enhanced susceptibility to dengue virus infection postvaccination"
www.science.org/doi/10.1126/...
@wanglaboratory.bsky.social
'FDA clears sepsis test that significantly reduces life-or-death diagnosis time.'
news.stanford.edu/stories/2025...
'FDA clears sepsis test that significantly reduces life-or-death diagnosis time.'
news.stanford.edu/stories/2025...
med.stanford.edu/news/all-new...
med.stanford.edu/news/all-new...
www.cell.com/cell-host-mi...

www.cell.com/cell-host-mi...

